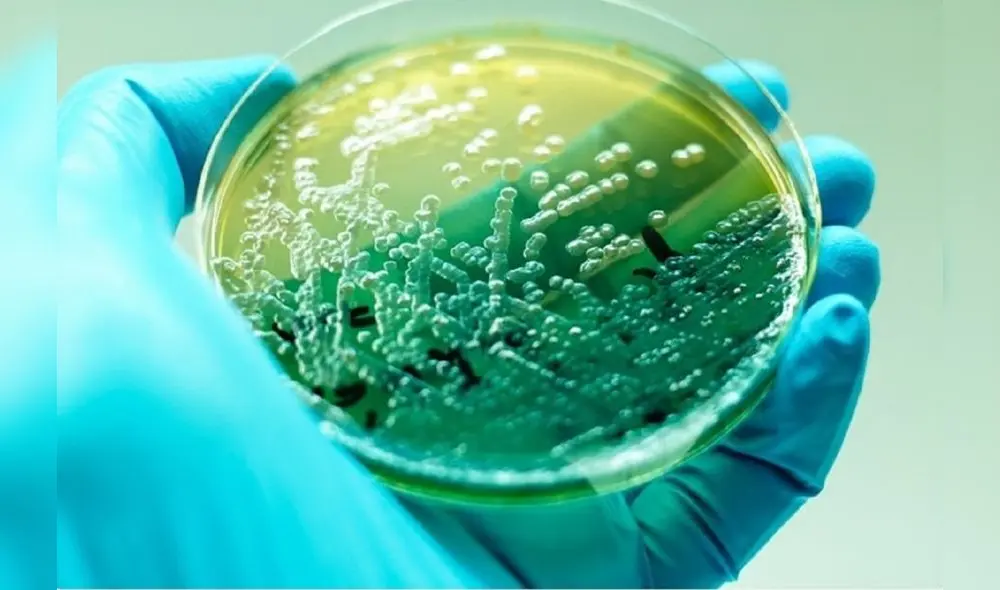
Bacterias

La Libertad: investigan sobre virus para combatir enfermedades infecciosas
Entre ellos el antibiótico pseudomonas aeruginosa, que según la OMS, es causante de diversos males.
- MTC confirma cierre del Serpentín de Pasamayo hasta 2028: vehículos de transporte público no podrán circular
- Riesgo en el mar: 157 playas fueron declaradas como “no saludables” a nivel nacional por el Minsa
Con el apoyo del Concytec, la Universidad Privada Antenor Orrego (UPAO), en la región La Libertad, viene investigando para obtener del medio ambiente una colección de bacteriófagos (virus propios de las bacterias).
Los cuales serán beneficiosos para combatir bacterias resistentes a los antibióticos como Pseudomonas aeruginosa, que según la Organización Mundial de la Salud (OMS) son causantes de enfermedades infecciosas nocivas.
TE RECOMENDAMOS
ÁLVARO PAZ DE LA BARRA EN VIVO Y MIRTHA VÁSQUEZ SE SALVA | ARDE TROYA CON JULIANA OXENFORD
Hospitales trujillanos
Este proyecto inició su trabajo recolectando muestras de Pseudomonas multirresistentes a antibióticos en los hospitales trujillanos de Belén, Regional Docente y Víctor Lazarte Echegaray.
Las mismas que serán analizados y destruidos mediante pruebas con bacteriófagos o fagos, desarrollados en el laboratorio de Microbiología Molecular y Biotecnología.
Objetivo del proyecto
El proyecto busca encontrar 30 cepas de Pseudomonas multiresistentes a los antibióticos. Luego identificar virus para cada una de estas cepas; después realizar un estudio genómico para descartar aquellos fagos portadores de genes de resistencia.
Y finalmente diseñar la formulación y probar su efectividad en animales de experimentación.
Ambientes intrahospitalarios
Se supo que la bacteria Pseudomonas aeruginosa está presente en espacios como agua, suelo e incluso en los alimentos.
Daños irreversibles
En el caso de la investigación se analizarán las identificadas en ambientes intrahospitalarios, ya que están asociadas a procesos infecciosos que pueden originar daños irreversibles. Principalmente en pacientes de cuidados intensivos.



















